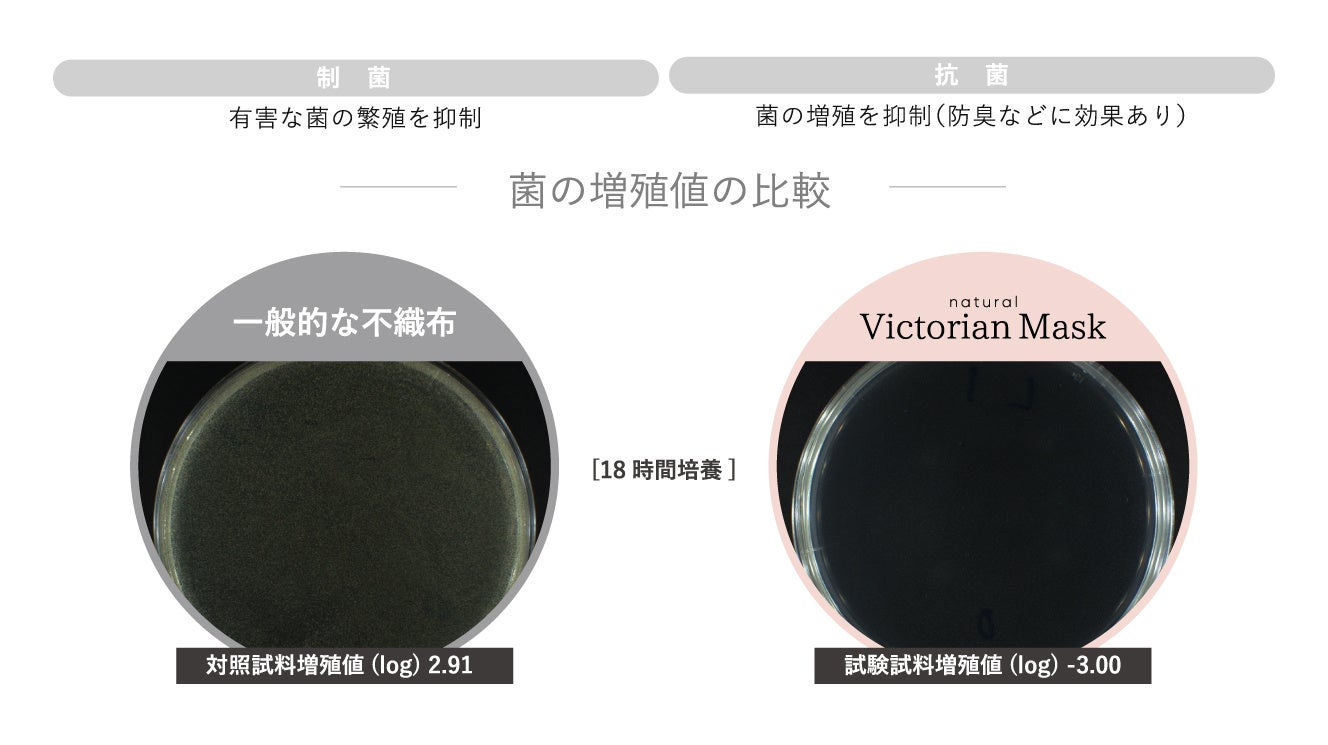

【先着1000名様限定】“美容皮膚科医師 推奨” natural Victorian Maskの35枚入りを購入していただいた方に「ポータブル加湿器」をプレゼント!Wチャンスで同商品が当たる企画も!
トウモロコシのでんぷんを主な原料とした弱酸性マスク natural Victorian Maskと、持ち運びやすい加湿器で、冬の乾燥対策!
美容皮膚科医師 推奨「natural Victorian Mask」の35枚入りセットを購入した 先着1000名様にポータブル加湿器をプレゼントするキャンペーンを開催します。
さらに、Instagramに投稿&フォローで同商品1か月分が抽選10名様に当たる企画も同時開催しております。
natural Victorian Maskの購入でポータブル加湿器をゲット!

なくなり次第終了!
“美容皮膚科 医師推奨マスク” natural Victorian Maskの35枚入りを公式サイトで購入いただいた
先着1000名の方に数量限定特典で乾燥しやすい冬に嬉しい「ポータブル加湿器」をプレゼント!
さらに・・・
「Wチャンスでnatural Victorian Mask1か月分が当たるかも⁉」
詳しくはページ下部、また下記のURLからご覧ください。
https://victorianmask.com/pages/2023-novelty-cp
マスク+加湿器でのどを潤して 風邪や感染症を予防しよう!
____________________________________________
【ポータブル加湿器 プレゼント条件】
①プロフィール記載のURLからVictorian Mask公式サイトに行く。
②対象商品のページにて【数量限定特典あり】を買い物カゴに入れて、ご注文完了までお進みください。
【期間】
2023年12月22日(金)~なくなり次第終了
【注意事項】
・当キャンペーンに関する個別のお問い合わせにはお答えしかねます。
・お届け先は日本国内に限ります。
・ノベルティの販売・換金・転売は御遠慮ください。
・発送は遅れる場合がございます。予めご了承ください。
・公式サイトでの購入に限ります。
・ノベルティは無くなり次第終了とさせていただきます。
・キャンペーン商品を2個以上購入いただきましてもお付けするノベルティは1個のみとなります。
カラーバリエーションのご紹介

『Victorian Mask公式サイトで販売中』
35・63・105・枚セット
※先着1000名様のポータブル加湿器のプレゼント対象は35枚セットのみです。
・White
・Light gray
・Lavender gray
・Nudy beige
公式オンラインショップ
Wチャンス!「Instagram フォロー&投稿キャンペーン開催中!」

【応募方法】
①Victorian Mask公式Instagramをフォロー
②キャンペーン時に対象商品を購入
③商品届き次第、商品の写真投稿
【応募対象となる投稿】
① #naturalVictorianMaskプレゼントキャンペーン のハッシュタグの記載
②タグ付け( @victorianmask_official )がされていること
※投稿受付期間:2024/1/4~1/29 23:59まで
※当選した方には、1/30ごろInstagramのDMでご連絡いたします。
【その他注意事項】
・当キャンペーンに関する個別のお問い合わせにはお答えしかねます。
・お届け先は日本国内に限ります。
・当選商品の販売・換金・転売は御遠慮ください。
・発送は遅れる場合がございます。予めご了承ください。
・当選商品の色はお選びいただけません。
Victorian Mask公式インスタグラム
https://www.instagram.com/victorianmask_official/
natural Victorian Maskについて


【弱酸性素材】敏感肌向けパッチテスト済・トウモロコシから生まれた不織布

【一日中清潔に】天然の制菌性と抗菌性
不織布に使用される植物由来のPLA 樹脂( ポリ乳酸)には、天然の抗菌性がございます。
一般的な不織布との比較試験により、PLA 樹脂(ポリ乳酸 ) の非常に高い制菌性と抗菌性が証明されております。
制菌:有害な菌の繁殖を抑制
抗菌:菌(ニオイ等)の繁殖を抑制
【安心の品質】ウイルスや花粉もしっかり防ぐ

肌にやさしいだけではなく、しっかりウイルスや花粉も防ぎます。

非金属ノーズワイヤー入りで顔にフィットしやすく、金属アレルギーでも安心。耳紐は、長時間つけても痛くなりにくいやわらか素材を採用。
マスクを通じて、環境問題に向き合う。
新型コロナウイルスの感染拡大により、不織布マスクの消費が急増すると同時に、不織布マスクが大量に廃棄されています。通常の不織布マスクの素材は、ポリエステルやポリプロピレンなどプラスチックが原料です。
適切に廃棄されない不織布マスクが年々増加し、海洋プラスチック問題の一因にもなっています。

世界では実に合計520億枚のマスクが生産され、そのうちの約3%が海に流出するとされています。
数にすると15億6千万枚という膨大な数のマスクが、自然界の中で完全に分解されることなく途方もない年月をかけて海を漂うことで、自然環境や生態系に影響を与えています。
この深刻な環境問題に私たちは向き合っていきます。
このプレスリリースには、メディア関係者向けの情報があります
メディアユーザー登録を行うと、企業担当者の連絡先や、イベント・記者会見の情報など様々な特記情報を閲覧できます。※内容はプレスリリースにより異なります。
すべての画像
